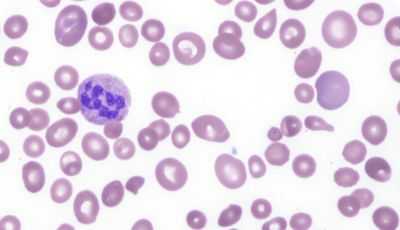

Мегалобластическая анемия за счет нарушения поглощения фолиевой кислоты
Добавил пользователь Skiper Обновлено: 29.01.2026
Раньше B12-дефицитную анемию (болезнь Аддисона – Бирмера) называли злокачественным малокровием или пернициозной анемией. Первым, кто заявил о существовании такой болезни и описал данный вариант, был врач из Англии Томас Аддисон, и произошло это еще в 1855 году. Позже немец Антон Бирмер сообщил о заболевании в более подробной форме, но случилось это лишь 17 лет спустя (1872). Однако ученый мир признал первенство за Аддисоном, поэтому по предложению французского врача Армана Труссо, патология стала называться именем автора, то есть, болезнью Аддисона.
Прорыв в изучении этого тяжелого недуга случился уже в 20 годах прошлого века, когда американские врачи Джордж Уипл, Уильям Мёрфи и Джордж Майнот на основе своих исследований заявили, что недуг поддается лечению, если в рационе больного будет присутствовать сырая печень. Они доказали, что В12-дефицитная анемия – врожденная несостоятельность желудка в выделении веществ, обеспечивающих всасывание витамина B12, за что в 1934 году были награждены Нобелевской премией по физиологии и медицине.
В настоящее время мегалобластную анемию, связанную с недостатком цианокобаламина (витамина В12), мы знаем, как В12-дефицитную анемию, а комбинированную форму, обусловленную дефицитом и витамина B12, и фолиевой кислоты (витамина B9), как В12-фолиеводефицитную анемию.
В чем сходство и в чем отличие
Как отмечено выше, В12-дефицитная и В12-фолиеводефицитная анемии входят в группу мегалобластных анемий, для которых характерно снижение продукции ДНК, что, в свою очередь, влечет нарушение пролиферации клеток, способных к быстрому делению. Это – клетки:
- Костного мозга;
- Кожных покровов;
- Слизистых оболочек;
- Желудочно-кишечного тракта.
Среди всех быстропролиферирующих клеток, гемопоэтические (кроветворные) проявляют наибольшую склонность к ускоренному размножению, поэтому симптомы малокровия стоят в числе первых клинических проявлений данных мегалобластных анемий. Нередки случаи, когда, помимо анемии (снижение уровня эритроцитов и гемоглобина), наблюдаются другие признаки гематологической патологии, например, уменьшение количества кровяных пластинок – тромбоцитов (тромбоцитопения), нейтрофильных лейкоцитов (нейтропения, агранулоцитоз), а также моноцитов и ретикулоцитов.
кровь при B12-дефицитной анемии
Почему эти варианты малокровия так взаимосвязаны и в чем их разница? Дело в том, что:
- Присутствие и непосредственное участие витамина В12 весьма необходимо для образования активной формы фолиевой кислоты, которая, в свою очередь, очень нужна для продукции тимидина – важного компонента ДНК. Данное биохимическое взаимодействие при участии всех необходимых факторов позволяет в полной мере обеспечить нормальное образование клеток крови и клеток ЖКТ (желудочно-кишечный тракт);
- На витамин В12 возложены и другие задачи – при его участии распадаются и синтезируются отдельные жирные кислоты (ЖК). При недостаточном содержании цианокобаламина данный процесс нарушается, и в организме начинает накапливаться вредная, убивающая нейроны, метилмалоновая кислота, а вместе с этим снижается продукция миелина – вещества, которое образует миелиновую оболочку, несущую электроизолирующую функцию для нервных клеток.
Что касается фолиевой кислоты, то распад ЖК в ее участии не нуждается и при ее недостатке нервная система не страдает. Мало того – если пациенту, имеющему дефицит В12 в качестве лечения прописать фолиевую кислоту, то непродолжительное время она будет стимулировать эритропоэз, но лишь до тех пор, пока она не окажется в избытке. Излишнее количество препарата заставит работать весь присутствующий в организме В12, то есть, даже тот, который был предназначен для обеспечения распада ЖК. Безусловно, к добру такая ситуация не приводит – еще больше поражаются нервные ткани, развиваются глубокие дегенеративные изменения спинного мозга с потерей двигательных и чувствительных функций (комбинированный склероз, фуникулярный миелоз).
Таким образом, недостаток витамина В12, наряду с нарушением пролиферации кроветворных клеток и развитием анемии, оказывает негативное воздействие на нервную систему (НС), в то время, как дефицит фолиевой кислоты влияет лишь на деление гемопоэтических клеток, но на здоровье нервной системы не отражается.
Значимость внутреннего фактора
Цианокобаламин из продуктов питания, попавших в ЖКТ, всасывается с помощью так называемого, внутреннего фактора (ВФ). Вот как это происходит:

Очевидно, почему такое большое значение уделяется внутреннему фактору, ведь если с ним все в порядке, то почти весь цианокобаламин, поступивший с пищей, благополучно попадет по месту назначения. В противном случае (при отсутствии ВФ) – только 1% витамина В12 методом диффузии просочиться сквозь кишечную стенку и тогда человек не получит нужного ему количества такого важного витамина.
Суточная потребность организма в цианокобаламине составляет от 3 до 5 мкг, а в запасе его находится от 4 до 5 граммов, стало быть, можно подсчитать, что, если полностью исключить поступление витамина В12 (например, при гастрэктомии), то запасы иссякнут через 3-4 года. А вообще, запас витамина B12 рассчитан на 4-6 лет, в то время как фолиевая кислота при отсутствии поступления исчезнет через 3-4 месяца. Отсюда можно сделать вывод, что дефицит В12 при беременности не грозит, если до того его уровень был в норме, а вот фолиевая кислота, если женщина не употребляла сырых фруктов и овощей, вполне способна упасть ниже допустимого предела и создать дефицитное состояние (развитие фолиеводефицитной анемии).
Витамин В12 содержится в продуктах животного происхождения, фолиевая кислота – почти во всех продуктах питания, однако цианокобаламин замечательно переносит термическую обработку в течение длительного времени и сохраняется для поступления в организм, чего нельзя сказать о фолиевой кислоте – после 15-минутного кипячения от этого витамина не останется и следа…
В чем причина дефицита этих витаминов?

Недостаток цианокобаламина может быть вызван следующими причинами:
- Низким поступлением с пищей витамина В12 (когда человек по собственной инициативе или в силу других причин недополучает продукты, несущие организму цианокобаламин: мясо, печень, яйца, молочные продукты), либо полным переходом на вегетарианство (в пище растительного происхождения витамин В12 трудно найти);
- Нарушением секреции внутреннего фактора, обусловленным атрофией слизистой, которая формируется по причине наследственной предрасположенности, воздействия токсических веществ, влияния антител и развития атрофического гастрита в результате этого. Подобные последствия подстерегают пациента в случае полного удаления желудка (гастрэктомия), в то время как потеря только части органа оставляет секрецию нетронутой;
- Отсутствием рецепторов, в которых нуждается внутренний фактор с целью своего связывания, что происходит при поражающей все отделы ЖКТ болезни Крона, дивертикулах и опухолях тонкой кишки, туберкулезе и резекции подвздошной кишки, кишечном инфантилизме (целиакии), хроническом энтерите;
- Конкурентным поглощением цианокобаламина в ЖКТ гельминтами или микроорганизмами, которые интенсивно размножаются после наложения анастомозов;
- Расстройством внешнесекреторной функции поджелудочной железы и следствием этого – нарушением расщепления протеина-R, что препятствует связыванию витамина В12 с внутренним фактором;
- Довольно редкой, полученной по наследству, аномалией – понижением уровня транскобаламина и нарушением перемещения цианокобаламина в костный мозг.
С витамином В9 все намного проще: он содержится почти во всех продуктах, замечательно всасывается в здоровом кишечнике и не испытывает нужды ни в каком внутреннем факторе. А проблемы возникают, если:
- Рацион в силу разных обстоятельств пациента крайне скуден;
- Человек, страдающий нервной анорексией, преднамеренно отказывается от еды;
- Возраст пациента расценивается, как пожилой;
- Алкоголик «трясется» от абстинентного синдрома при длительном запое (не до полноценной еды – она не лезет);
- Имеет место синдром нарушенного кишечного всасывания (заболевания ЖКТ: болезнь Крона, целиакия, опухоли кишечника и др.) – основная причина В12-фолиеводефицитной анемии;
- Увеличивается потребность в фолиевой кислоте, что бывает при беременности, некоторых кожных заболеваниях (псориаз, дерматит), нарушении утилизации (алкоголизм, врожденные болезни обмена фолатов).
Кстати, недостаток витамина В9 не так уж редко наблюдается у людей, которые вынуждены длительно принимать противосудорожные препараты, в том числе, фенобарбитал, поэтому данный факт следует учитывать при назначении подобной терапии.
Как проявляются В12- и В9-дефицитные состояния?

Коль описываемые состояния относят к анемиям, то, само собой разумеется, что для них будут характерны все симптомы малокровия:

- Быстрое наступление усталости даже при минимальной физической активности, слабость, снижение работоспособности;
- Эпизоды потемнения в глазах;
- Склонность к гипотонии (снижение артериального давления);
- Нарушение дыхания (желание ускорить шаг или другие движения вызывают одышку);
- Периодические головные боли, часто кружится голова;
- Нередко отмечается нарушение ритма (тахикардия);
- Кожные покровы бледные, отдают легкой желтизной (субиктеричность);
- В полости рта развиваются проблемы с характерными для глоссита признаками: сосочки атрофированы, поверхность языка – лакированная, язык распухает и болит;
- Возможно увеличение печени и селезенки;
- Отечность нижних конечностей;
- Частый стул, который, впрочем, может чередоваться с запорами;
- Заметное снижение аппетита и, соответственно, веса.
Ввиду того, что при недостатке цианокобаламина имеет место триада синдромов (поражения крови, ЖКТ и нервной системы), а при дефиците фолиевой кислоты страдания нервной системы не отмечаются, следующие симптомы, свидетельствующие о вовлечении в патологический процесс нервной системы, будет относиться только к В12-дефицитному состоянию:
- Фуникулярный миелоз (дегенеративная патология спинного мозга), который по выраженности не коррелирует с клиническими проявлениями анемии;
- Периферическая полинейропатия с мышечной слабостью, расстройством чувствительности и снижением сухожильных рефлексов;
- В иных случаях на почве анемии наблюдаются депрессивные состояния, нарушение памяти, редко – психические расстройства.
Следует отметить, что В12- и фолиеводефицитные состояния быстро прогрессирующим течением не отличаются и на симптомы не особо богаты. Заболевания до недавнего времени были отнесены к патологии преклонного возраста, правда, в последние годы наметилась тенденция к «омоложению» – такого рода анемии стали встречаться у молодых людей.
Диагностика
Первый этап лабораторных исследований заставляет заподозрить мегалобластную анемию:

- Общий анализ крови (ОАК) – типичный для подобных состояний: пониженный уровень эритроцитов и гемоглобина, тромбоцитопения, нейтропения с полисегментированностью, ЦП обычно выше 1, макроцитоз, пойкилоцитоз, анизоцитоз, в эритроцитах – тельца Жолли, кольца Кебота;
- Повышенные значения билирубина за счет несвязанной фракции в биохимическом анализе крови (БАК).
Учитывая, что похожую картину периферической крови может давать другая гематологическая патология (гипопластические и апластические состояния, гемолитическая анемия, лейкоз), больному в обязательном порядке назначают пункцию спинного мозга, в котором находят мегалобласты (характерный признак В12-дефицитной анемии), гигантских размеров мегакариоциты и клетки гранулоцитарного ряда.
Как правило, после лабораторных тестов (или параллельно с ними) пациента ждет «страшная процедура» – фиброгастроскопия (ФГС), по данным которой видно, что слизистая оболочка желудка атрофирована.
Между тем, дальнейшая диагностика В12-дефицитной анемии требует ее отмежевания от малокровия, связанного с недостатком витамина В9. Очень важно тщательно собрать анамнез пациента: изучить его образ жизни и питания, досконально выявить симптомы, исследовать состояние сердечно-сосудистой и нервной системы, но уточнение диагноза все же требует лабораторных исследований. И здесь следует отметить, что в любом случае дифференциальная диагностика этих двух анемий сложна для обычных лабораторий, ведь создается необходимость определения количественных значений витаминов, однако:
- Микробиологический метод далек от совершенства и дает только приблизительные результаты;
- Радиоиммунологические исследования недоступны жителям деревень и маленьких городов, поскольку проведение анализа требует участия современного оборудования и высокочувствительных реагентов, которые являются привилегией больших городов.
В таком случае для дифференциальной диагностики был бы полезен анализ мочи, определяющий в ней количество метилмалоновой кислоты: при В12-дефицитной анемии ее содержание заметно увеличивается, тогда как при фолиеводефицитном состоянии уровень остается неизменным.
Лечение
Лечение недостатка фолиевой кислоты преимущественно ограничивается назначением таблетированных форм витамина В9 в дозе 5-15 мг/сутки. Правда, если диагноз фолиеводефицитной анемии все же остается под вопросом, то целесообразно начать лечение с внутримышечного введения цианокобаламина. Однако наоборот – нельзя, ведь при В12-дефицитной анемии применение фолиевой кислоты еще больше усугубит ситуацию.

Что касается лечения В12-дефицитной анемии, то оно основано на трех принципах:
- В полной мере насытить организм цианокобаламином, чтобы и на выполнение функциональных обязанностей хватило и в запас отложилось;
- За счет поддерживающих доз постоянно пополнять запасы;
- По возможности стараться не допустить развития анемического состояния.
Само собой разумеется, что главным в лечении недостатка В12 будет назначение цианокобаламина с учетом изменений со стороны крови и выраженности неврологической симптоматики, если она имеет место.
Таким образом:
- Обычно лечение начинается с внутримышечного введения цианокобаламина в дозе 500 мкг каждый день и оксикобаламина – 1000 мкг через день;
- Если имеет место выраженные симптомы поражения нервной системы (фуникулярный миелоз), то доза В12 увеличивается до 1000 мкг (каждый день), а, кроме этого, добавляется по 500 мкг аденозилкобаламина в таблетках, который в обмене участие принимает, но на кроветворение не влияет;
- Появление в анализе крови гипохромии красных клеток крови на фоне лечебных мероприятий или в случае смешанных форм болезни (В12- + железодефицитная анемия) является основанием для назначения препаратов железа;
- К переливанию эритроцитной массы прибегают в особых случаях: если явно обозначились признаки кислородного голодания головного мозга и симптомы анемической энцефалопатии, имеет место прогрессирующая сердечная недостаточность и при подозрении на развитие анемической комы – очень опасного для жизни пациента состояния;
- Одновременно назначается терапевтическое воздействие на факторы, которые, возможно, стали причиной дефицита витамина В12, с такой целью проводится: дегельминтизация (препараты и дозы зависят от вида гельминтов), лечение заболеваний желудочно-кишечного тракта, хирургическая операция при раке желудка, нормализация кишечной флоры, разрабатывается диета, предусматривающая достаточное поступление витамина B12 в организм.
Буквально через несколько дней от начала терапии производится контрольный подсчет ретикулоцитов – ретикулоцитарный криз будет свидетельством, что тактика лечения выбрана правильно.
После того, как состояние крови будет признано нормальным, пациента переводят на поддерживающую терапию: сначала каждую неделю, а потом каждый месяц больному вводят 500 мкг В12, а, кроме этого, раз в полгода назначают 2-3 недельный курс витаминотерапии (поддерживающее лечение витамином В12).
Мегалобластическая анемия за счет нарушения поглощения фолиевой кислоты
Мегалобластическая анемия за счет нарушения поглощения фолиевой кислоты - фолиевокислых солей. В разнообразных синдромах неполноценности поглощения (и пищеварения) поглощение фолиевокислых солей страдает в такой степени, что, иногда, развивается мегалобластическая анемия, в принципе за счет полидефицитности.
В отдельных случаях фолиевый дефицит может, в свою очередь, выступить в роли преобладающего патофизиологического фактора в связи с поражением кишечного эпителия.
а) При тропическом спру — болезнь невыясненной этиологии, характеризующаяся стеатореей с неполноценным поглощением жиров и углеводов, гипоальбуминемией, гипокальциемией, неполноценным поглощением фолиевой кислоты (и витамина В12) — видимо основным механизмом является дефицит фолиевой кислоты: подвозимая с пищей фолиевокислая соль не поглощается в связи с угнетением кишечных конъюгаз под воздействием бактериального обсеменения кишечника, возможно посредством продуктов распада желчных солей (Бернштейн).
Доказательством этому служат иногда изумительные результаты пероральной терапии фолиевой кислотой (лекарственной), как в отношении фолиевого дефицита, так и кишечного синдрома и гистологических поражений; в отдельных случаях проведение антибиотикотераиии дает положительные результаты.

Участие фолиевой кислоты в метаболизме
б) При глютеновой энтеропатии (спру, нетропическое спру) — болезнь, развивающаяся в связи с сенсибилизацией к глиадину (не распадающаяся по причине отсутствия N-глютамилпептидазы) — происходит тяжелая атрофия кишечных ворсин с последующим нарушением поглощения жиров, кальция, железа и отдельных витаминов.
Показатель фолиевокислой соли в сыворотке занижен, пробы на поглощение фолиевой кислоты нарушены у большинства больных, одновременно с тяжельми гистологическими поражениями слизистой тощей кишки (неподдающиеся лечению фолиевой кислотой).
в) Неполноценное поглощение фолиевокислых солей отмечается также в ряде иных кишечных поражений (в основном затрагивающих отрезок тощей кишки), таких как, иссечение кишечника, лимфоматозная инфильтрация или хроническое воспаление, амилоидоз, болезнь Whipple и пр., крупное иссечение желудка.
г) Пониженное поглощение фолиевокислых солей (видимо за счет угнетения конъюгаз) вызывают, также, спирт и отдельные медикаменты (противосудорожные и пр.), однако в основном, их действие отражается на уровне использования клетками этих солей.
д) В небольшом числе известных случаев врожденной неполноценности поглощения фолиевой кислоты (Lanzkowsky) генетический недостаток касается механизма активного переноса через кишечную клетку (и поступления из плазмы в спинномозговую жидкость). При этом была выявлена мегалобластическая анемия с предельно низким содержанием фолиевокислых солей в крови и поражением нервной системы (отсутствовали гистологические поражения кишечника). На мегалобластоз воздействовали положительно парентеральным введением фолиевой кислоты (или внутрь, весьма крупными дозами).
Редактор: Искандер Милевски. Дата обновления публикации: 18.3.2021
Мегалобластическая анемия за счет нарушения расхода фолиевой кислоты
Мегалобластическая анемия за счет нарушения расхода фолиевокислых солей:
а) Противофолиевые средства (метотрексат, аметоптерин) — неактивные структурные аналоги фолиевой кислоты, применяемые в терапии острой лейкемии и других злокачественных заболеваний — блокируют дигидрофолатредуктазу (а в меньшей мере и другие ферменты) (Бертино и сотр.) и тем самым определяют дефицит коферментов FH4 с последующим развитием мегалобластоза.
Одновременно наблюдается выход фолиевокислой соли из запаса и усиленное выделение с мочой (за счет понижения обратного поглощения канальцами).
Их влияние на клеточное деление пропорционально коэффициенту этого процесса. При этом даже в случае применения терапевтических доз отмечаются мегалобластические изменения и лейкотромбоцитопения. а в случае передозировки — начинается страдание эпителиев пищеварительного тракта (изъязвления полости рта и кишечника), выпадение волос и пр. К другим вторичным последствиям относятся аборт, риск возникновения дефектов у плода.
Чрезмерно крупные дозы приводят к костномозговой аплазии путем блокирования клеточной дифференциации и даже процесса цитоплазматического синтезирования (Hryniuk). Токсическое действие противофолиевых средств можно устранить назначением фолиновой кислоты (лейковорин) одновременно с противофолиевым препаратом, или в течение первых, последующих его введению часов.

б) Ряд иных медикаментов могут взаимодействовать с фолиевой кислотой посредством еще не выясненных, во всех случаях, механизмов. После длитерльного использования этих медикаментов возможно появление признаков фолиевой недостаточности, от простого уменьшения фолиевокислой соли в сыворотке, до легкой формы мегалобластической анемии.
К числу этих лекарственных средств относятся пириметамин (используемый для лечения малярии и токсоплазмоза), противосудорожные средства (дифенилгидантоин, фенобарбитал и примидон — влияющие также на рассасывание кишечником), некоторые туберкулостатические препараты (циклосерин, возможно изониазид), местранол (противозачаточное средство).
в) Алкоголизм (фактор, участвующий в развитии других видов анемии). Его сочетание с дефицитным фолиевокислыми солями питанием быстро приводит к понижению показателя их количества в сыворотке и мегалобластозу, сопровождающегося сидеробластозом (с наличием признаков дефицита пиридоксина) (Eichner и сотр.).
Алкоголь угнетает кишечные конъюгазы (видимо и чрезклеточный перенос), образование запаса и метаболизации фолиевокислых солей в печени, равно как и отдельные ферменты в кровяных клетках (в то же время он оказывает на последние и непосредственно токсическое действие, с ранней вакуолизацией цитоплазмы).
г) Инфекция ускоряет развитие мегалобластоза на фоне скрытого фолиевого дефицита. Нарушение расхода подсказано понижением, в частности, фолиевокислой соли в сыворотке и частичная неэффективность лечения фолиевой кислотой.
д) Фолиевый дефицит выявлен также при ревматоидном артрите (у 2/3 больных занижен показатель фолиевокислой соли в сыворотке), гемохроматозе, лучевой болезни, почечной недостаточности и многих других заболеваниях. При недостаточности аскорбиновой кислоты (которая, видимо, участвует в реакции восстановления FH2 в FH4) в некоторых случаях анемия приобретает мегалобластический характер, при этом на нее можно положительно воздействовать назначением аскорбиновой или фолиевой кислот (крупными дозами).
При железодефиците могут наблюдаться низкий показатель фолиевокислой соли в сыворотке и незначительные мегалобластические изменения в костном мозге (крупные миелоциты), однако положительные результаты достигаются только применением железа.
е) Врожденные недостатки ферментов, отражающиеся на метаболизм фолиевокислых солей. До настоящего времени из этой категории выявлены: дефицит формиминотрансферазы (Arakawa), при котором реакция FIGlu резко положительная, происходят тяжелые поражения нервов (в связи с вовлечением системы (b) синтезирования пуринов), показатель фолиевокислой соли в сыворотке весьма высокий, бывают непостоянные или легкие мегалобластические изменения (синтезирование ДНК не попадает под непосредственное влияние); дефицит циклогидролазы (Arakawa и сотр.) с поражением нервов но отрицательной реакцией FIGlu; один случай дефицита N3-метил-FН4-трансферазы (Arakawa) и один (вероятный) — дефицита FН2-редуктазы (Nystrom).
Мегалобластная анемия: причины, развитие и виды, симптомы, лечение
Мегалобластная анемия (МА) или как её также принято называть – пернициозная анемия (хотя такое название подразумевает дефицит исключительно витамина B12) – патология, отнесенная к группе приобретенных и/или передаваемых по наследству гематологических заболеваний, возникающих на почве нарушения синтеза рибонуклеиновой (РНК) или дезоксирибонуклеиновой кислоты (ДНК).
Для мегалобластных анемий весьма характерным признаком является изменение клеток эритроидного ряда: размера (большой), дифференцировки ядра и цитоплазмы (асинхронная), размещения хроматина в ядре (не свойственное нормальным клеткам).
Мегалобластная анемия – типичные представители
Болезнь формируется по причине недостатка отдельных витаминов (в частности, B12 и B9). Это происходит потому, что синтез ДНК зависим от количества данных веществ в организме. Кроме этого, выработку дезоксирибонуклеиновой кислоты могут расстроить отдельные (редкие) наследственные аномалии ферментов, принимающих участие в биохимических процессах, влияющих на продукцию ДНК.

Типичными представителями этой гематологической патологии являются:
- B12-дефицитная анемия (болезнь Аддисона-Бирмера, пернициозная анемия, злокачественное малокровие) – самая частая форма. Она обусловлена недостатком цианокобаламина, может быть приобретенной по причине заболеваний верхнего отдела кишечника (тонкая кишка) либо передаваемой по наследству и зависимой от продукции и выделения внутреннего фактора (ВФ), либо от всасывания в кишечнике и отсутствия транспортного протеина, который переносит цианокобаламин (транскобаламин). Наследственная анемия становится заметной уже у детей младшего возраста;
- Фолиеводефицитная анемия (недостаток витамина B9) – наблюдается намного реже, нежели дефицит витамина B12, к тому же, изолированный дефицит фолиевой кислоты не ведет к столь серьезным последствиям, которые развиваются в отсутствие цианокобаламина;
- Сочетанный вариант – B12-фолиеводефицитная анемия. Комбинированная форма, обусловленная недостатком витаминов B12 и B9, встречается довольно редко и, как правило, возникает по причине нарушения всасывания данных веществ в кишечнике.
Почему так важно поступление достаточного количества цианокобаламина и фолиевой кислоты в организм человека? Все дело в том, что они принимают участие и играют не последнюю роль в транспортировке лабильных метильных групп метионина, в которых нуждается «строительство» ДНК. Как только уровень В12 снижается или он исчезает, эта реакция резко идет на спад, что сильно сказывается на созревании ядра. При сохраненной функции цитоплазмы, ядро делиться «не спешит» – этот процесс сильно запаздывает (происходит то, что называют «асинхронной дифференцировкой ядра и цитоплазмы»). В таких условиях сама клетка «пускается в рост» и приобретает огромные размеры.
Что дает старт болезни
Очевидно, что основным виновником развития патологии признается нарушение всасывания упомянутых выше витаминов в кишечнике. Какие предпосылки могут способствовать подобным нарушениям?
Гематологи обычно ссылаются на три основные причины:

- Отсутствие гликопротеина, называемого внутренним фактором (ВФ), и вырабатываемого специальными клетками тела и фундального отдела желудка. Неимение ВФ становится результатом аутоиммунного атрофического гастрита, в условиях которого начинают появляться «блокирующие» антитела (они не позволяют ВФ и цианокобакламину вступать во взаимодействие), а также антитела «связывающие» (эти АТ соединяются с внутренним фактором или с готовым блоком «ВФ + В12», инактивируя его);
- Заболевания тонкого кишечника (средней и нижней трети), где, собственно, и осуществляется всасывание цианокобаламина (гранулематозный энтерит – болезнь Крона, целиакия – непереносимость глютена, удаление большого участка тонкой кишки, новообразования);
- Появление конкурентов, «присваивающих» витамин В12, который был предназначен для всасывания. Например, конкурентами нормального всасывания может выступать широкий лентец либо бактерии, усиленно размножающиеся и забирающие питательные вещества при синдроме слепой кишечной петли (стаз тонкой кишки, застойная кишечная петля).
Таким образом, каждая из перечисленных причин способна нарушить процесс всасывания важных для организма элементов и запустить механизм развития мегалобластной анемии. Следует заметить, что, недополучая витамин B12, организм активно накапливает вредные жирные кислоты, которые несколько позже становятся причиной формирования неврологической симптоматики (нарушается образование миелина нервной ткани), которая весьма характерна для данной патологии. Кстати, фолиевой кислоты это не касается, поскольку она не участвует в распаде жирных кислот, а, стало быть, не заставляет страдать нервную систему.
Симптомы болезни

картина крови при мегалобластной анемии
Любая болезнь у разных людей может проявлять себя по-разному, однако в отношении мегалобластной анемии можно выделить ведущую триаду симптомов, которые будут иметь место практически у всех больных:
- Отсутствующее в норме мегалобластное кроветворение в костном мозге, дает значительные изменения в периферической крови. Анализ показывает:
мегалобласты и другие изменения в крови
- малокровие (анемия) – уменьшение количества красных клеток крови – эритроцитов и снижение уровня красного пигмента крови – гемоглобина;
- гиперхромию (насыщенная окраска увеличенных в размерах эритроцитов);
- пойкилоцитоз (изменение формы красных клеток крови);
- анизоцитоз: макроцитоз (клетки большого размера) и в большей степени – мегалоцитоз (размер красных кровяных телец может превышать 8, а то и 12 микрон);
- мегакариоцитоз – появление гигантских клеток костного мозга, имеющих большое ядро;
- нормобластоз – присутствие в мазках крови ядерных форм клеток эритроидного (красного) ряда (как известно, эритроциты, циркулирующие в периферической крови, ядра не имеют);
- в красных клетках крови замечаются остатки ядерной субстанции (включения в виде телец Жолли либо колец Кобота);
- в анализе крови также может быть снижено количество других форменных элементов: тромбоцитов, нейтрофилов, моноцитов.
- Клинически, а также при инструментальном обследовании, явно прослеживаются признаки поражения ЖКТ:
- теряется аппетит, снижается вес;
- атрофируется слизистая желудка;
- соляная кислота в желудочном соке полностью исчезает (ахлоргидрия), поскольку, вследствие атрофии слизистой, обкладочные клетки отмирают и перестают ее продуцировать (кислотность желудочного сока – 0).
- По причине недостатка цианокобаламина в течение длительного времени начинает испытывать страдания нервная система, что проявляется формированием фуникулярного миелоза (комбинированного склероза). Клинически – наблюдаются симптомы поражения спинного мозга:
- парестезии;
- нарушение чувствительности;
- парезы и параличи;
- выраженная мышечная слабость
Очевидно, что данная гематологическая патология, сопровождаемая непомерным увеличением красных клеток крови и изменением в их ядре, при прогрессировании и отсутствии адекватной терапии может сделать человека полным инвалидом. Нарушения образования миелина при дефиците В12 приводят к весьма серьезным последствиям: со временем теряется не только поверхностная, но и глубокая мышечная чувствительность, «отказывают ноги» (паралич нижних конечностей), органы таза перестают нормально функционировать (недержание мочи и кала, импотенция и т. д.). Не зря за пернициозной анемией сохранилось определение – «злокачественная».
Лечение и рекомендации на всю жизнь
Лечение мегалобластной анемии заключается в назначении ударных доз цианокобаламина в первые три дня (до 1000 γ в сутки), особенно, если появились признаки дегенеративных изменений спинного мозга (двигательные и чувствительные расстройства), затем дозу снижают до 400 – 500 γ каждый день до того, пока уровень гемоглобина не придет в норму. В среднем курс лечения продолжается месяц – полтора.
Фолиевую кислоту, как правило, одновременно не назначают, даже если имеет место ее дефицит при недостатке витамина B12 (применение фолиевой кислоты возможно только при изолированном варианте – фолиеводефицитной анемии, с которой, кстати, бороться намного легче и проще, нежели с недостатком кобаламина). Насколько эффективно назначенное лечение – покажет анализ, произведенный через 5-7 дней от начала терапии (увеличение количества молодых форм эритроцитов – ретикулоцитоз, является положительным признаком). Если же успеха от лечебных мероприятий не наблюдается, то необходимость продолжать диагностический поиск остается.
Следующим этапом лечения мегалобластной анемии является закрепляющая терапии, суть которой состоит в еженедельном введении 400 – 500 γ цианокобаламина в течение двух месяцев.
Переливание крови (эритроцитарной массы) назначается только в случаях, если значения гемоглобина падают ниже 50 г/л.
При выписке на домашний режим больной от врача получает рекомендации, касающиеся профилактики обострений болезни:
- Лечение хронических заболеваний, которые стали причиной формирования этой патологии;
- Коррекция диеты (отмена вегетарианства, насыщение рациона мясными продуктами, листовыми овощами и фруктами, содержащими данные вещества);
- Отмена лекарственных средств, признанных «виновниками» нарушения синтеза ДНК;
- Профилактические курсы витамина B12 (8 – 10 инъекций 1 раз в 6 месяцев на протяжении нескольких лет или всей оставшейся жизни, если причину заболевания никаким способом устранить невозможно).
Рисунок: продукты питания для профилактики дефицита витамина B12

Заподозрить мегалобластную анемию получается уже при первом общем анализе крови (ОАК). Поскольку даже самые современные («навороченные») анализаторы не способны уловить те морфологические изменения в эритроцитах (см. выше), которые свойственны данной патологии, то исследование не должно доверяться исключительно аппарату, пусть и самому «умному». Хотя и он, наверняка, обнаружит некоторые сдвиги в ОАК. Обычно любая, уважающая себя лаборатория, придерживается «золотых стандартов» и мазок в обязательном порядке просматривается врачом под микроскопом. Однако болезнь не принадлежит к случайным находкам, поэтому первичная диагностика опирается на жалобы пациента и клинические симптомы:
- Слабость, усталость, снижение общей физической активности и трудоспособности;
- Эпизодически наступающая темнота в глазах;
- Снижение уровня АД (гипотония);
- Частые головокружения и головные боли;
- Учащенное сердцебиение;
- Признаки изменения слизистой полости рта по типу глоссита;
- Возможно увеличение размеров селезенки (спленомегалия) и печени (гепатомегалия);
- Отеки ног;
- Склонность к поносам, хотя запоры также не исключены, то есть, эти неприятные состояния могут чередоваться между собой;
- Потеря аппетита, вкусовые нарушения, отсюда – снижение массы тела.

Далее последует более углубленная диагностика:
- Биохимический анализ крови (БАК) – он покажет повышение не конъюгированного (не связанного) билирубина, а также, скорее всего, изменение показателей сывороточного железа и значений лактатдегидрогеназы – ЛДГ;
- ФГДС (фиброгастродуоденоскопия), которая позволит определить состояние слизистой желудка (признаки атрофии);
- Пункция спинного мозга, поскольку лабораторные признаки похожи на таковые при гемолитической и апластической анемии;
- Дифференциальная диагностика – уточнение формы мегалобластной анемии (B12-дефицитная, недостаток фолиевой кислоты или комбинированный вариант).
Своевременная диагностика мегалобластной анемии очень важна для здоровья пациента, ведь опоздание или диагностическая ошибка (к счастью, она случается крайне редко) может привести к развитию анемической комы. Клиника ее довольно тяжела: больной не приходит в сознание, тяжело дышит, его пульс заметно учащен, артериальное давление снижено, кожные покровы отдают лимонным оттенком (при пернициозной анемии возможен усиленный гемолиз кровяных телец), возможно появление тонических и клонических судорог. Больной может погибнуть…
Есть ли особенности у детей?
У детей мегалобластная анемия в наибольшей степени носит наследственный характер и имеет несколько форм:
- Расстройство всасывания цианокобаламина может быть обусловлено поражением эпителиального слоя тонкой кишки и отсутствием тетрагидрофолата в клетках, который является активной формой витамина B9 (при этом, содержание внутреннего фактора остается в норме);
- Мегалобластная анемия, вызванная наследственной недостаточностью внутреннего фактора, характеризуется уменьшением (иногда значительным) выделения ВФ обкладочными клетками слизистой желудка (тип наследования – аутосомно-рецессивный);
- Дефицит переносящего В12 белка – транскобаламина (аутосомно-рецессивное наследование) абсолютно не виден при исследовании плазмы крови (значения кобаламина остаются в пределах нормы), зато в тканях – глубочайший дефицит (для В12 нет «транспортного средства», чтобы проникнуть в ткани);
- Очень редкая форма, которая наблюдается у детей, достигших подросткового возраста – ювенильная пернициозная анемия.
У детей с наследственной формой симптомы (отказ от еды, рвота, сухость и шелушение кожных покровов, признаки атрофического глоссита, частые пневмонии) проявляются уже на первом втором, реже на третьем, году жизни.

Диагностика болезни преимущественно основывается на морфологическом исследовании периферической крови и костного мозга, где обнаруживаются признаки мегалобластного кроветворения.
Лечение, в принципе, как и у взрослых: симптоматическое и назначение цианокобаламина по схеме.
Кроме этого существует ряд очень редких врожденных заболеваний, для которых характерно нарушение выработки дезоксирибонуклеиновой кислоты, а в качестве главного симптома выступает мегалобластная анемия. Вот, к примеру, некоторые из них:
- Оротовая ацидурия – нарушение обмена пиримидинов;
- Тиамин-зависимая МА, природа которой так и остается невыясненной, хотя известно, что наследование идет по аутосомно-рецессивному пути;
- Врожденная мальабсорбция фолатов (аутосомно-рецессивный тип наследования) – расстройство всасывания фолатов в кишечном тракте и переноса их из кишечника в кровеносное русло и из кровотока через гематоэнцефалический барьер;
- Наследуемые по аутосомно-рецессивному типу врожденные расстройства обмена фолатов (например, недостаток активности фермента ДГФР – дигидрофолатредуктазы);
- Синдром Лиш-Найана (патологический ген находится в Х-хромосоме).
Некоторые из этих болезней задерживают умственное и физическое развитие, дают богатую неврологическую симптоматику. Практически все эти врожденные аномалии в каждом конкретном случае требуют своего отдельного лечения, поскольку витамин B12 оказывается просто неэффективным.
Микроцитарная анемия

Чтобы синтезировать гемоглобин, человеку необходимо железо. Если его не хватает, организм не получает необходимого количества кислорода. Дефицит может возникать по разным причинам. В основном из-за недостаточного количество железа в пище, его плохого усвоения в организме, а также кровопотерь. Итак, недостаток железа приводит к снижению уровня гемоглобина, что в свою очередь ведет к малокровию, по-другому железодефицитной или микроцитарной анемии. Такой вид является самым распространенным. К тому же он чаще наблюдается среди женщин — около 20 % не обладают необходимым количеством железа в организме.
Информацию из данного раздела нельзя использовать для самодиагностики и самолечения. В случае боли или иного обострения заболевания диагностические исследования должен назначать только лечащий врач. Для постановки диагноза и правильного назначения лечения следует обратиться к профильному специалисту.

Макроцитарная анемия
Анемия бывает разной. Если после анализа у обследуемого в показателях указан диаметр меньше 8 микрон, то это признак микроцитарного малокровия, если же он превышает этот показатель, тогда анемии присваивается тип — макроцитарная. Оба вида возникают из-за нарушения свойств крови — понижения уровня концентрации гемоглобина. В свою очередь, такая анемия бывает гемолитической и фолиево-дефицитной. Для гемолитической характерна потеря эритроцитов (красных кровяных телец) в результате их ускоренного разрушения. Фолиево-дефицитная анемия обусловлена нехваткой фолиевой кислоты, которая вызывает замедление процесса созревания эритроцитов в костном мозге.
Симптомы
К сожалению, сегодня до одной трети всего взрослого населения страдают таким синдромом, как микроцитарная гипохромная анемия. При этом налицо у заболевших общая слабость в организме. Снижается работоспособность, человек постоянно чувствует себя уставшим, страдает рассеянным вниманием и сонливостью. Меняются предпочтения в еде. Происходит потеря аппетита. При прогрессировании могут возникнуть нарушения обоняния и вкуса. У взрослых, особенно у пожилых людей, недостаток гемоглобина ведет к тому, что кровь перестает насыщаться кислородом, и возникает тяжелая форма анемии. Появляются:
- одышка;
- сбой сердечного ритма;
- обмороки.
Внешние проявления при макроцитарном синдроме в основном затрагивают кожные покровы. Они начинают желтеть. При этом губы приобретают бледный цвет, ногти становятся светлее. Могут возникать:
- частые боли в области живота;
- жжение языка;
- увеличение размеров печени и селезенки.
Схожими симптомами с микроцитарной станут недомогание, слабость, учащенный пульс, нарушение сна, а также другие расстройства вегетативной системы.

Причины данных анемий
Недостаток железа либо нарушение его всасывания — залог получения такого диагноза, как микроцитарная гипохромная анемия. Дефицит поступления этого элемента с пищей вкупе с его потерей во время кровотечений (например, менструационных, маточных либо желудочно-кишечных) повышает риск возникновения этого синдрома. Особенно нуждаются в железе:
- дети грудного и подросткового возраста;
- беременные;
- пациенты с глистной инвазией;
- больные опухолевыми заболеваниями.
Макроцитарная анемия, в свою очередь, возникает вследствие дефицита витаминов группы В (в основном В12) и фолиевой кислоты. Такой недуг — результат неправильного образа жизни, в частности проблем с печенью из-за чрезмерного употребления алкоголя или агрессивных медикаментов. Она также наблюдается у беременных и больных онкологическими заболеваниями. Может возникнуть у людей с проблемами в функционировании щитовидной железы и у пациентов с дисфункцией стволовых клеток костного мозга.
К какому врачу обратиться?
При появлении симптомов и подозрении на наличие анемии необходимо записаться на прием к такому врачу как:
Читайте также:
